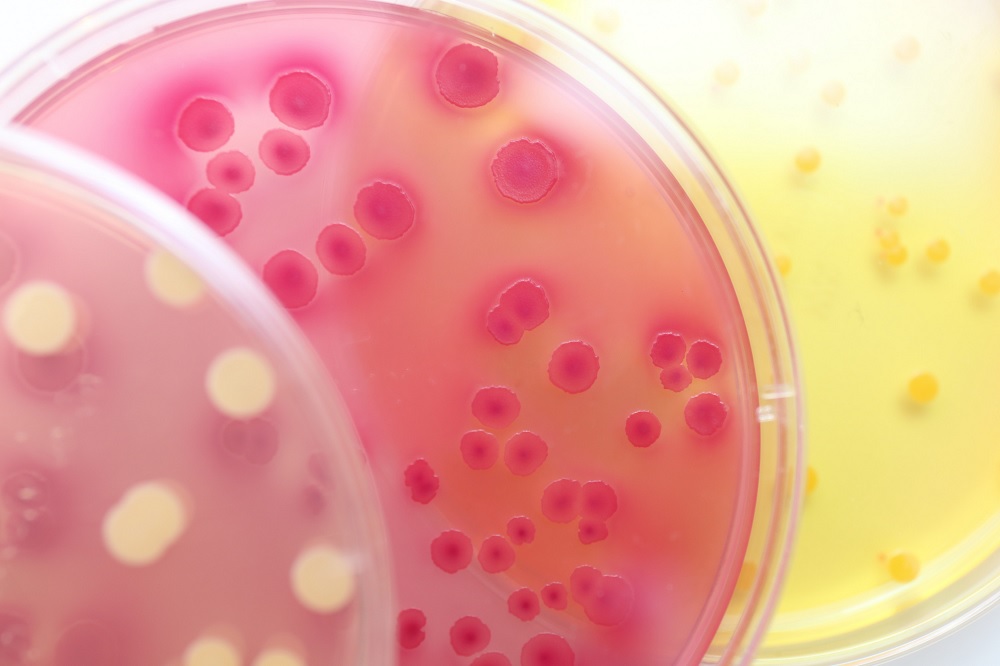

Are you curious about ATP testing and why it’s necessary to test for it in food and drink? Adenosine triphosphate (ATP) is an energy source found in almost all living cells which can be used by organisms like bacteria, yeast, mould and viruses to multiply. By doing careful ATP testing on a regular basis, companies are able to make sure that the quality of their products remain above safety levels and reduce any risks associated with contamination. Read this blog post for more information about what ATP testing is, why its important to test food and drinks for it, how you can do so confidently at home or professionally, as well as what could happen if you don’t!
What is Adenosine Triphosphate (ATP)?
Adenosine Triphosphate (ATP) is a molecule that is involved in energy storage and release in living things. It acts as the main energy source for cells. To ensure control and safety, ATP testing is often performed on food and drink products in order to check that they are both of high enough quality, and also contamination-free. If ATP testing isn’t done regularly it can have serious implications – if contaminated food was to be consumed, it could lead to dangerous illnesses or even fatalities. Therefore, regular testing of ATP levels in products is highly advised to keep customers safe from any health risks associated with substandard or dangerous foods.
How is it used to test food and drink safety levels
Adenosine triphosphate, or ATP, testing is a key tool used to ensure food and drink safety levels by providing quick results to identify contamination. This type of control testing rapidly detects organic matter, ensuring that products meet the necessary standards before they reach consumers. If ATP tests are not conducted, there could be serious consequences due to increased risks associated with foodborne illness and unsafe foods and beverages. Food producers use atp testing to protect their customers, holding themselves accountable for providing high quality products that meet regulatory requirements.
The importance of ATP Testing in the Food and Beverage Industry
Adenosine Triphosphate (ATP) testing is an important aspect of the food and beverage industry. This type of control testing helps to identify potential sources of contamination, such as surface bacteria or foreign matter, that could potentially harm people who consume the products. As a result, it is a valuable tool in helping to protect consumers by ensuring food safety standards are being met. Without ATP testing, there is a risk that dangerous levels of contamination could go undetected and lead to health risks for those consuming the products. Therefore, it is essential that all food and beverage companies practice proper ATP monitoring to guarantee a safe and healthy product for their customers.
Potential risks associated with not conducting ATP tests
Adenosine triphosphate (ATP) testing is an important tool for controlling the safety of food and beverages. ATP testing is used to detect contamination in products that could lead to potential health risks for consumers. Without conducting and adhering to ATP tests, a business cannot ensure their products are free from potentially hazardous bacteria or microorganisms that have the capability to cause food poisoning, harm or even death. ATP testing is essential for businesses that handle food and drink in order to avoid any unexpected risks associated with non-compliance.
In conclusion, Adenosine Triphosphate (ATP) is a vital source of energy for living cells and is an important element when it comes to food and beverage safety testing. This type of testing identifies contaminants in food and drink products that can make people ill, meaning that ATP tests are an essential part of the food and beverage industry. It’s important to note that the failure to conduct ATP tests can have serious consequences as this could lead to contamination going unnoticed and people becoming ill. Thus, although it is time-consuming and demanding, thoroughly conducting ATP tests in the workplace should be prioritized in order to ensure food safety.
